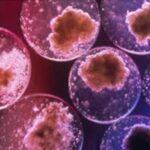

Convegno cellule staminali: Agrigento- Favara 2-3 Dicembre. Hotel Dioscuri di san Leone.
Convegno cellule staminali: Agrigento- Favara 2-3 Dicembre. Hotel Dioscuri di san Leone.
Una ulteriore speranza sarà comunicata prossimamente alle donne che sono state colpite di tumore alla mammella al prossimo Convegno sulle cellule staminali che si svolgerà dal 2 al 3 dicembre in Agrigento.
Infatti, oltre a presentare i risultati che indicano come è possibile sconfiggere il male nelle donne colpite, il dottor Giovanni Ciuffo, chirurgo oncoplastico della mammella presso l’istituto clinico Zucchi di Monza, comunicherà i risultati ottenuti recentemente nella ricostruzione della mammella con trapianto autologo di tessuto adiposo, impiegando ovviamente le cellule staminali capace di rigenerare i tessuti.
L’intervento del dottor Ciuffo è molto atteso perché sappiamo come tante donne che hanno subito l’esportazione della mammella desiderano riavere un equilibrio del corpo anche per l’aspetto estetico che l’organo rappresenta nell’aspetto femminile.
La presenza del dottor Ciuffo al Convegno è segno come in Italia i cervelli ci sono e offrono un notevole contributo alla ricerca scientifica, senza andare all’estero.

















